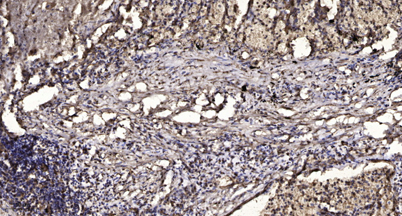

Overview
-
 Western Blot analysis of various cells using MEK-3 Polyclonal Antibody
Western Blot analysis of various cells using MEK-3 Polyclonal Antibody -
 Western Blot analysis of K562 cells using MEK-3 Polyclonal Antibody
Western Blot analysis of K562 cells using MEK-3 Polyclonal Antibody -
 Western blot analysis of lysates from Jurkat cells, treated with serum 20% 15', using MAP2K3 Antibody. The lane on the right is blocked with the synthesized peptide.
Western blot analysis of lysates from Jurkat cells, treated with serum 20% 15', using MAP2K3 Antibody. The lane on the right is blocked with the synthesized peptide. -
Immunohistochemical analysis of paraffin-embedded human Squamous cell carcinoma of lung. 1, Antibody was diluted at 1:200(4° overnight). 2, Tris-EDTA,pH9.0 was used for antigen retrieval. 3,Secondary antibody was diluted at 1:200(room temperature, 45min).
Immunohistochemical analysis of paraffin-embedded human Squamous cell carcinoma of lung. 1, Antibody was diluted at 1:200(4° overnight). 2, Tris-EDTA,pH9.0 was used for antigen retrieval. 3,Secondary antibody was diluted at 1:200(room temperature, 45min).
关闭
在线咨询
Online consultation
-
在线咨询
-
技术支持

关注微信公众号



 下载说明 ①
下载说明 ①




